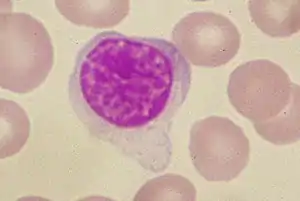

{{free media}}"Upstream Binding Factor (UBF) is important for activation of ribosomal RNA transcription and belongs to a family of proteins containing nucleic acid binding domains, termed HMG-boxes, with similarity to High Mobility Group (HMG) chromosomal proteins."[1]
Chromosomal proteins
"Most HMG box proteins contain two or more HMG boxes and appear to bind DNA in a relatively sequence-aspecific manner (5, 13, 15, 16 and references therein). [...] they all appear to bind to the minor groove of the A/T A/T C A A A G-motif (10, 14, 18-20)."[2]
"Previous studies in lymphocytes have described two DNA-binding HMG box proteins, TCF-1 and LEF-1, with affinity for the A/TA/TCAAAG motif found in several T cell-specific enhancers."[3]
"The high mobility group-1 (HMG) box was originaly identified by Tjian and co-workers in the transcription factor UBF as a region of homology to HMG-1 proteins (Jantzen et al., 1990). UBF reportedly contained four such regions of -80 amino acids; one of these boxes was shown to mediate DNA binding."[3]
"Interestingly, the sequence-specific HMG boxes characterized to date display high afinity to the A/TA/TCAAAG motif despite a low level of amino acid homology (typically <25% identity)."[3]
"Human LEF-1 was originally identified as a T cell-specific protein binding to the TTCAAAG motif in the TCR-α enhancer (Waterman et al., 1991)."[3]
"As analysed by gel retardation, the Sox-4 HMG box indeed bound to the AACAAAG motif (probe MWε-1; Figure 2B, lane 1). As described for other HMG boxes, Sox-4 interacted with DNA bases within the minor groove: substitution of A/T pairs for I/C pairs, which leaves the surface of the minor groove intact (Star and Hawley, 1991), had no apparent effect on binding affinity (lanes 2 and 4)."[3]
Consensus sequences
"In mammals, the Tcf/Lef family consists of four genes: Tcf‐1, Lef‐1, Tcf‐3 and Tcf‐4. All TCF/LEF proteins display several common structural features (48,49). They contain a nearly identical DNA‐binding domain, the HMG box, recognizing the consensus sequence A/T A/T CAAA."[4]
See also
References
- ↑ Gregory P. Copenhaver, Christopher D. Putnam, Michael L. Denton and Craig S. Pikaard (1994). "The RNA polymerase I transcription factor UBF is a sequence-tolerant HMG-box protein that can recognize structured nucleic acids". Nucleic Acids Research 22 (13): 2651-7. https://academic.oup.com/nar/article-pdf/22/13/2651/7122053/22-13-2651.pdf. Retrieved 2017-04-05.
- ↑ Vincent Laudet, Dominique Stehelin and Hans Clevers (1993). "Ancestry and diversity of the HMG box superfamily". Nucleic Acids Research 21 (10): 2493-501. https://academic.oup.com/nar/article-pdf/21/10/2493/4086740/21-10-2493.pdf. Retrieved 2017-04-05.
- 1 2 3 4 5 Marc van de Wetering, Mariette Oosterwegel, Klaske van Norren and Hans Clevers (1993). "Sox-4, an Sry-like HMG box protein, is a transcriptional activator in lymphocytes". The EMBO Journal 12 (10): .3847-3854. https://www.ncbi.nlm.nih.gov/pmc/articles/PMC413668/pdf/emboj00082-0143.pdf. Retrieved 2017-02-13.
- ↑ Tomas Valenta, Jan Lukas, Vladimir Korinek (2003). "HMG box transcription factor TCF‐4’s interaction with CtBP1 controls the expression of the Wnt target Axin2/Conductin in human embryonic kidney cells". Nucleic Acids Research 31 (9): 2369-80. doi:10.1093/nar/gkg346. https://academic.oup.com/nar/article/31/9/2369/1080420/HMG-box-transcription-factor-TCF-4-s-interaction. Retrieved 2017-04-05.